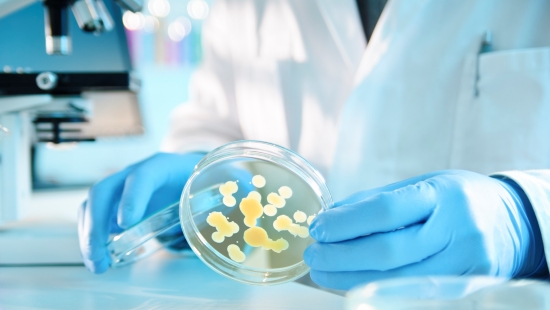

微生物控制
从最精细的专业化造纸机到最大、生产最快的造纸机,我们为世界各地各种造纸机提供完整的纸浆和纸张微生物控制方案。艺康结合原水处理、造纸流程、设备及废水运营管理方面的经验,提供合适的化学制剂、新型给水系统,以及通过现场专家安全提供的业内领先的实时监测和控制服务。
产品、设备和服务
了解我们的微生物控制剂产品组合
我们找不到与以下关键词匹配的结果:“".
从最精细的专业化造纸机到最大、生产最快的造纸机,我们为世界各地各种造纸机提供完整的纸浆和纸张微生物控制方案。艺康结合原水处理、造纸流程、设备及废水运营管理方面的经验,提供合适的化学制剂、新型给水系统,以及通过现场专家安全提供的业内领先的实时监测和控制服务。
了解我们的微生物控制剂产品组合
我们找不到与以下关键词匹配的结果:“".